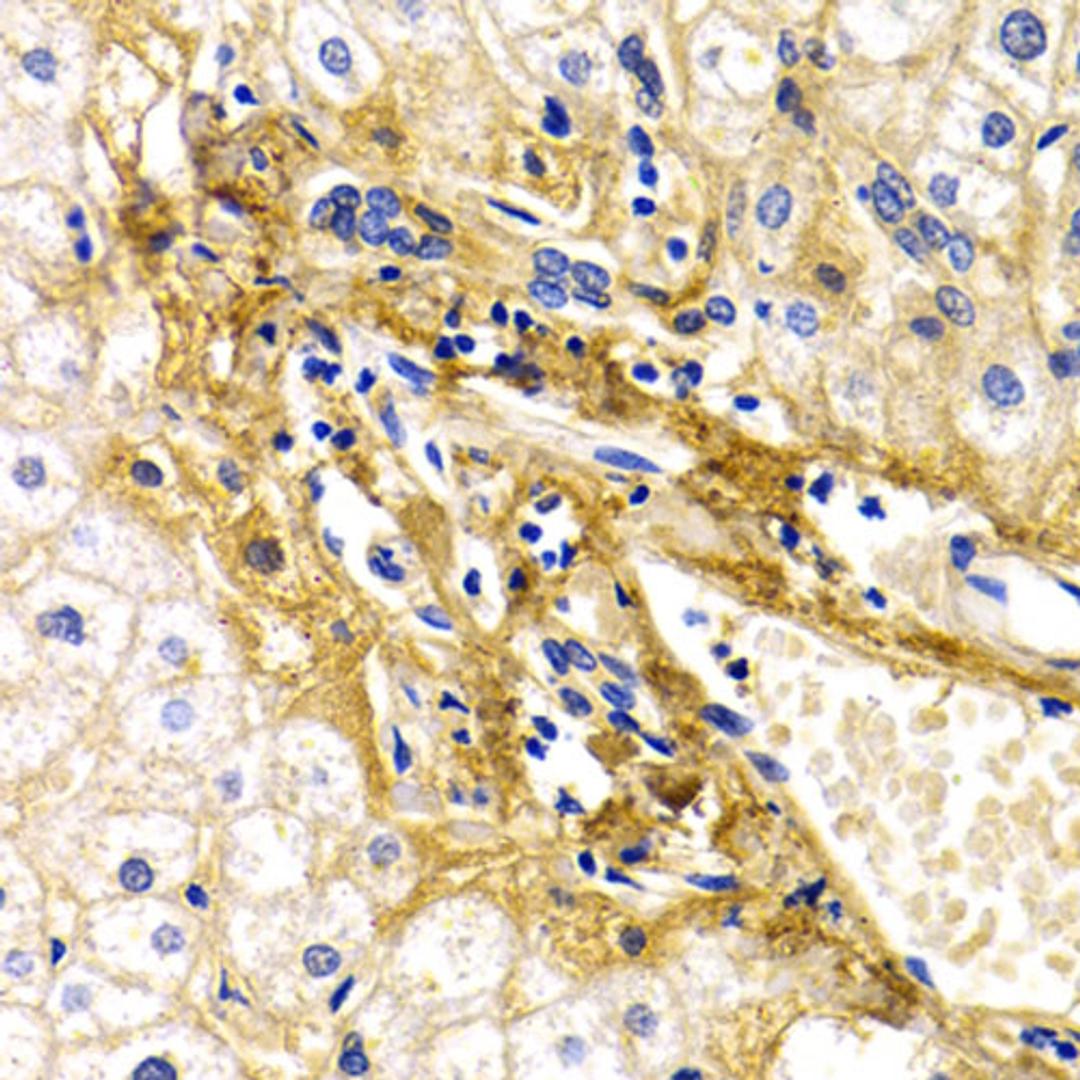
Immunohistochemistry - CFH antibody (A2166)

Product & ReviewsAntibodies
CFH Rabbit pAb
Product Details
- Cat. No.
- A2166
- Type
- Primary Antibody
- Clonality
- Polyclonal
- Host
- Rabbit

The supplier does not provide quotations for this antibody through SelectScience. You can search for similar antibodies in our Antibody Directory.
Description
This gene is a member of the Regulator of Complement Activation (RCA) gene cluster and encodes a protein with twenty short consensus repeat (SCR) domains. This protein is secreted into the bloodstream and has an essential role in the regulation of complement activation, restricting this innate defense mechanism to microbial infections. Mutations in this gene have been associated with hemolytic-uremic syndrome (HUS) and chronic hypocomplementemic nephropathy. Alternate transcriptional splice variants, encoding different isoforms, have been characterized.
Biological Information
- Clonality: Polyclonal
- Host: Rabbit
- Reactivity: Human